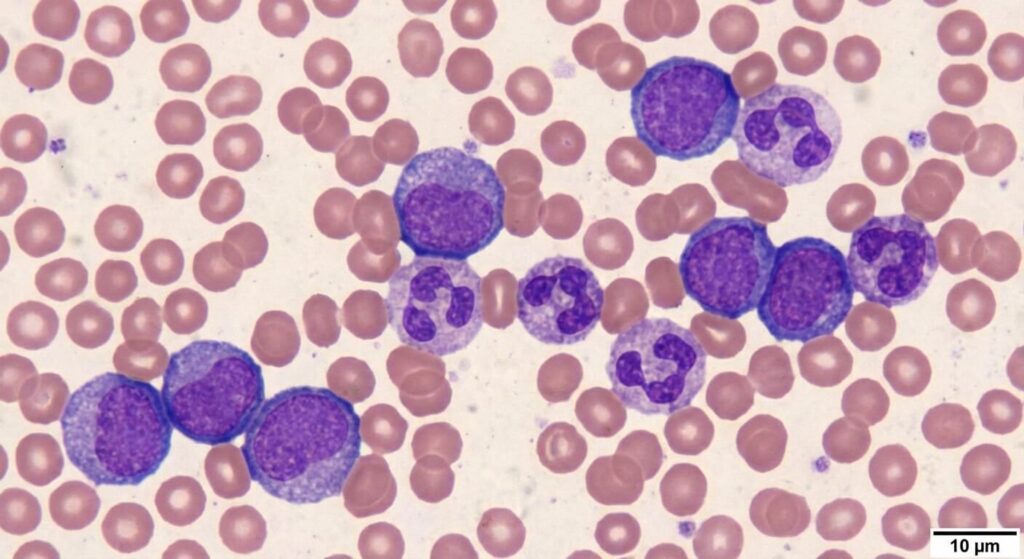
Analyse hématologique au microscope révélant la présence physiologique de cellules sanguines immatures

Le parcours de suivi prénatal est jalonné de nombreux examens biologiques visant à garantir la sécurité de la mère et du fœtus. Recevoir les résultats de son bilan sanguin mensuel est devenu une routine, jusqu’au jour où une ligne anormale attire l’attention de la future maman. Découvrir le terme « myélémie » inscrit en gras sur l’analyse de sa Numération Formule Sanguine (NFS) provoque souvent une recherche paniquée sur Internet. Les résultats des moteurs de recherche associant ce mot à des maladies hématologiques lourdes, comme la leucémie, déclenchent une angoisse fulgurante, pourtant totalement disproportionnée face à la réalité obstétricale.
La grossesse n’est pas un état pathologique, mais c’est un bouleversement métabolique et physiologique monumental. Le corps de la femme enceinte déploie des efforts colossaux, adaptant son volume sanguin et son système immunitaire pour accueillir la vie. L’apparition temporaire d’une légère myélémie dans la circulation sanguine s’inscrit, dans l’immense majorité des cas, dans ce processus d’adaptation naturel. Décrypter le mécanisme de fabrication des globules blancs et comprendre comment la moelle osseuse réagit aux stimuli de la gestation est indispensable pour lire son bilan biologique avec sérénité avant le prochain rendez-vous chez la sage-femme.
Ce qu’il faut retenir
- 🩸 La définition médicale : Une myélémie désigne le passage transitoire de globules blancs immatures (jeunes) de la moelle osseuse vers la circulation sanguine générale.
- 🤰 Un phénomène très courant : Chez la femme enceinte, une très faible myélémie (souvent inférieure à 5 %) est considérée comme une réaction physiologique normale et bénigne.
- 📈 La surchauffe de l’usine sanguine : Ce phénomène accompagne souvent l’hyperleucocytose (augmentation normale des globules blancs) liée à la grossesse, la moelle osseuse travaillant à plein régime.
- 🩺 Le contexte clinique prime : Si la future maman n’a pas de fièvre prolongée, d’infections sévères ou d’anomalies majeures des globules rouges, cette ligne du bilan n’a aucun caractère de gravité.
Le grand bouleversement sanguin de la femme enceinte
Pour comprendre l’apparition de ces cellules au nom effrayant, il faut s’intéresser au fonctionnement de notre usine de production sanguine : la moelle osseuse. En temps normal, la moelle fabrique les globules blancs (leucocytes) et les garde bien au chaud jusqu’à ce qu’ils soient totalement matures et prêts à défendre l’organisme, avant de les relâcher dans le sang.
Durant la grossesse, le volume sanguin de la mère augmente de près de 40 %. Le système immunitaire est également sous haute tension, ce qui se traduit par une augmentation très classique et physiologique du nombre de globules blancs (on parle d’hyperleucocytose gravidique). Face à cette demande frénétique de production, l’usine osseuse est parfois débordée. Sous l’effet des hormones et du stress inflammatoire mineur inhérent à la gestation, la barrière de la moelle osseuse devient légèrement perméable. Elle laisse alors « fuiter » dans le sang quelques globules blancs qui n’ont pas tout à fait terminé leur formation (les myélocytes, métamyélocytes ou promyélocytes). L’automate du laboratoire détecte cette présence prématurée et affiche le terme « myélémie ».
Interpréter la numération formule sanguine sans paniquer
La présence de ces cellules immatures ne constitue pas une maladie en soi, mais un symptôme biologique qu’il faut contextualiser. En dehors de l’hyperactivité liée strictement à la grossesse, la myélémie est le marqueur universel d’une moelle osseuse qui a été fortement stimulée.
Chez la femme enceinte, cette stimulation peut provenir d’un facteur annexe extrêmement banal. Une simple infection urinaire (très fréquente pendant la grossesse), un vilain rhume, ou une supplémentation massive en fer pour lutter contre l’anémie fœtale suffisent à provoquer un « coup de fouet » sur la moelle osseuse, entraînant une myélémie passagère. Le médecin ou la sage-femme regardera le bilan dans sa globalité. Si la myélémie est de faible intensité (de l’ordre de 1 à 3 %), que le taux d’hémoglobine est correct et que les plaquettes sont stables, le professionnel de santé classera ce résultat sans suite, rassurant instantanément la future mère.
Tableau : Comprendre l’origine d’une myélémie
| Contexte clinique du patient | Origine de la myélémie | Degré d’inquiétude et prise en charge |
|---|---|---|
| Patiente enceinte (2ème ou 3ème trimestre) sans fièvre. | Hyperleucocytose physiologique. | Bénin. Simple surveillance biologique de routine. |
| Patiente enceinte + forte fièvre + brûlures urinaires. | Réponse immunitaire à une infection bactérienne. | Modéré. Traitement de l’infection (antibiotiques) nécessaire. |
| Patient non enceinte, anémie sévère et ganglions. | Pathologie hématologique suspectée. | Élevé. Orientation vers un hématologue pour examens approfondis. |
L’avertissement de la Sage-Femme Échographiste
« L’accès direct aux résultats de laboratoire via Internet est une merveille technologique, mais c’est un cauchemar psychologique pour les femmes enceintes. La plupart des laboratoires impriment les valeurs de référence standard, conçues pour un adulte en dehors de tout contexte de grossesse. La femme enceinte compare ses chiffres et voit des étoiles ou du rouge partout : trop de leucocytes, une myélémie à 2 %, un taux de fer dans les chaussettes. C’est normal ! Le corps d’une femme qui porte la vie ne rentre plus dans les cases de la biologie classique. Ne tapez jamais vos résultats sanguins sur Google, attendez toujours mon coup de téléphone pour l’interprétation. »
La surveillance médicale : Quand faut-il approfondir ?
Bien que la dédramatisation soit de mise, les professionnels de la périnatalité maintiennent une vigilance rigoureuse. L’apparition d’une myélémie n’est ignorée que si elle reste modérée, fugace et isolée. Lors de la prise de sang suivante, prescrite un mois plus tard, la disparition ou la stabilisation de ce taux confirmera son origine bénigne liée à l’état gravidique. En revanche, si la proportion de cellules sanguines immatures augmente significativement, ou si elle s’accompagne d’une chute inexpliquée et brutale des plaquettes (thrombopénie) ou des globules rouges, l’obstétricien demandera l’expertise d’un hématologue. Un frottis sanguin manuel sera réalisé pour examiner visuellement les cellules, écartant définitivement tout doute sur une éventuelle pathologie de la moelle osseuse indépendante de la grossesse.
Foire Aux Questions (FAQ)
🦠 Un rhume peut-il provoquer une myélémie pendant la grossesse ?
Absolument. Toute infection, même virale et d’apparence bénigne comme un rhume, une angine ou une bronchite, provoque une réaction de défense de l’organisme. Le corps demande en urgence de nouveaux globules blancs pour combattre les intrus. La moelle osseuse accélère la cadence et relâche par précipitation quelques globules blancs encore jeunes (les myélocytes). Si vous avez fait votre prise de sang alors que vous étiez enrhumée, l’explication est toute trouvée.
💉 Dois-je refaire une prise de sang immédiatement ?
Non, ce n’est généralement pas nécessaire, à moins que votre gynécologue ou sage-femme ne l’exige expressément. Refaire une prise de sang le lendemain montrerait probablement le même résultat, car le corps met un certain temps à rétablir son équilibre sanguin. Le médecin se fiera à votre état clinique (avez-vous de la fièvre, des douleurs, une fatigue anormale ?) et préférera souvent contrôler l’évolution de la Numération Formule Sanguine lors de votre bilan mensuel obligatoire du mois suivant.
👶 Est-ce que cette anomalie sanguine peut avoir un impact sur mon bébé ?
Une myélémie physiologique (liée à l’augmentation normale du volume sanguin ou à une petite infection sans gravité) n’a strictement aucun impact sur le développement du fœtus. Les globules blancs de la mère ne traversent pas la barrière placentaire pour attaquer le bébé. Cette ligne sur votre bilan sanguin ne reflète que l’état de surchauffe de votre propre système immunitaire, et non un problème de santé chez l’enfant que vous portez.







